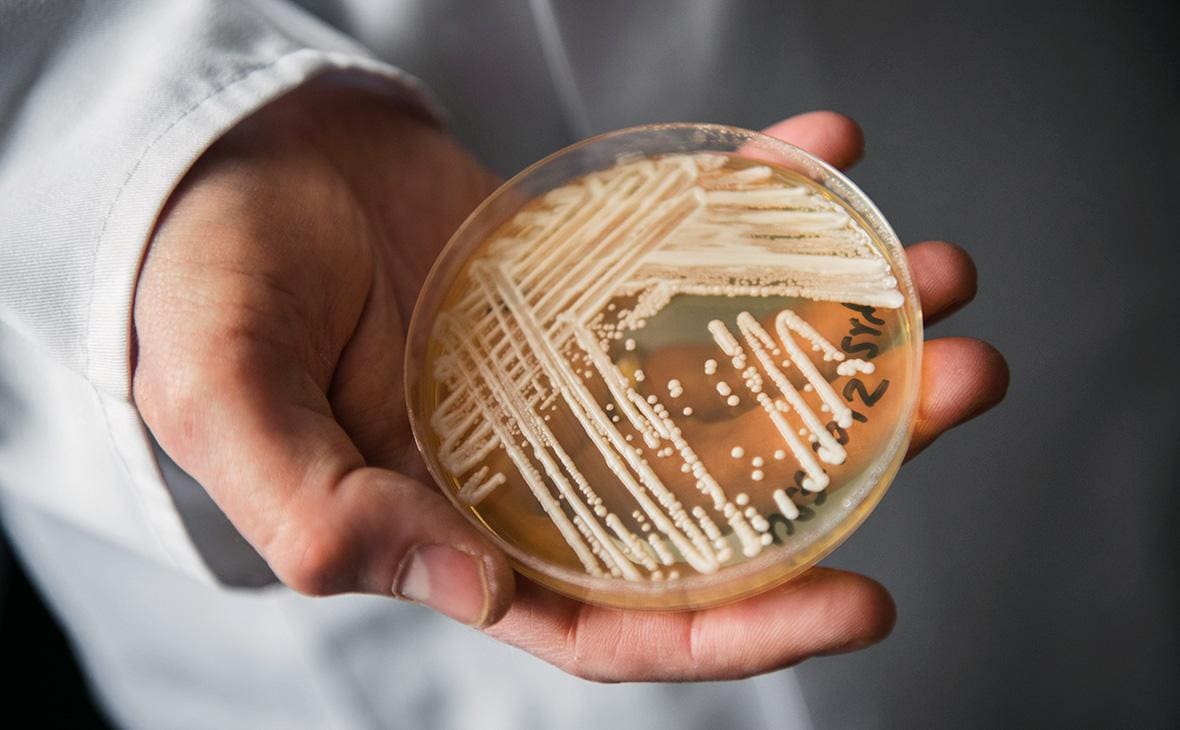

Candida Auris, переименованная в 2023 году в Candidozyma Auris, — лекарственно-устойчивая грибковая инфекция — быстро распространяется в европейских больницах. Центр европейского контроля и профилактики заболеваний (ECDC) призывает к срочным мерам.
Инфекция особенно опасна для пациентов в тяжёлом состоянии и тех, кто уже имеет сопутствующие симптомы. Количество случаев растёт, вспышки увеличиваются, и несколько стран сообщают о продолжающемся местном распространении, предупреждает ECDC.
За десять лет, с 2013 по 2023 год, страны ЕС/ЕЭЗ зарегистрировали более 4 000 случаев заражения.
«В 2023 году 18 стран сообщили о 1 346 новых случаях», — отмечается в сообщении ECDC.
При этом специалисты считают, что официальная статистика отражает лишь верхушку айсберга, поскольку во многих странах нет систематического наблюдения. Румыния, наряду с Испанией, Грецией, Италией и Германией, входит в число стран с наибольшим числом случаев за десятилетие.
Первый случай Candidozyma Auris в странах ЕС/ЕЭЗ был зарегистрирован в 2014 году, затем последовали локальные вспышки. В последние годы фиксируется постоянный рост числа случаев. Три страны (Кипр, Франция и Германия) зарегистрировали отдельные вспышки, тогда как в Греции, Италии, Румынии и Испании инфекция приобрела эндемический характер, и выделить отдельные очаги невозможно. В этих странах между первым зарегистрированным случаем и региональной эндемичностью прошло пять-семь лет.
ECDC предупреждает:
«Быстрое распространение C. Auris вызывает серьёзное беспокойство и указывает на высокий риск дальнейшего распространения в европейских системах здравоохранения. Контроль будет становиться всё более сложным. Раннее выявление и оперативное применение национальных мер по предотвращению и контролю инфекций (PCI) всё ещё могут смягчить последствия для госпитализированных пациентов».
На текущий момент только 15 из 36 стран, участвовавших в исследовании, имеют национальные руководства по профилактике и контролю инфекции, хотя доступ к лабораториям сравнительно хорош: 29 стран располагают референсной лабораторией или экспертом по микологии, а 23 страны предоставляют больницам тестирование. Национальные исследования в Нидерландах и Франции также показали ограниченную подготовку и внедрение таких руководств.
Симптомы инфекции
C. Auris распространяется особенно быстро в больницах и долгосрочных учреждениях ухода. Она может вызывать:
-
инфекции ушей, ран, мочевыводящих путей, крови;
-
сепсис;
-
резистентность некоторых штаммов к противогрибковым препаратам, что осложняет лечение.
Инфекция опасна для пациентов с хроническими заболеваниями и ослабленным иммунитетом, при этом здоровые люди могут быть носителями без симптомов. Симптомы зависят от локализации инфекции: лихорадка, озноб, сильная усталость, низкое артериальное давление, учащённый пульс, возможна гипотермия и боль в ухе.
C. Auris передаётся через контакт с заражёнными поверхностями или пациентами. Распространение по воздуху не зафиксировано.
Профилактика
Диагностика сложна и требует специальных тестов. Лечение осложняется устойчивостью к противогрибковым препаратам, иногда применяются комбинации препаратов в высоких дозах.
Гораздо проще предотвратить распространение инфекции:
-
тщательная гигиена рук персонала;
-
дезинфекция поверхностей (грибок может выживать днями и неделями);
-
стерилизация медицинского оборудования;
-
использование антибиотиков только при бактериальной инфекции;
-
изоляция пациентов при подозрении или подтверждении инфекции;
-
скрининг пациентов и посетителей больницы.
Эти меры помогают значительно снизить риск распространения Candidozyma Auris в медицинских учреждениях.